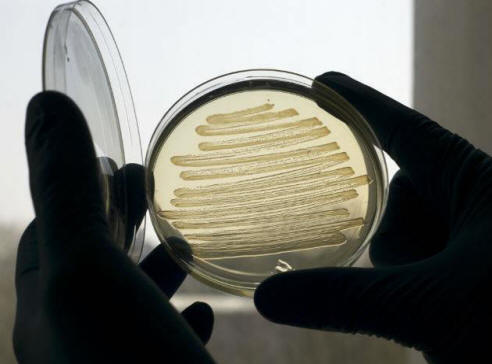

Géntechnológiával egy Escherichia coli törzs (Escherichia coli), a tudósok arra kényszerítették a baktériumot, hogy cukorré váljon üzemanyag, amely összetételében nagyjából hasonlít a szokásos dízelolajra üzemanyag. Ha egy ilyen folyamatot folyamatosan aktiválnak, akkor tetszik a szintetikus üzemanyag jó alternatíva lehet fosszilis tüzelőanyagok. Tanulmány, amelynek eredményei voltak megjelent a PNAS magazinban, szintetikus biológus, John Love vezetésével (John Love) az Exeteri Egyetemen. Fotók nyílt forrásból
Fotók nyílt forrásból
“Autó gyártókat, eladókat akarunk az üzemanyagok és a járművezetők még a szokásos benzin között sem észrevették a különbséget és az új találmányunk “- mondja Love. A tervek szerint Az Európai Unióban az üvegházhatású gázok kibocsátását 2050-re csökkenteni kell 80% -kal. Ennek eredményeként 2020-ra a teljes összeg legalább 10% -a A felhasznált üzemanyagnak bioüzemanyagnak kell lennie. De tovább manapság a legtöbb biodízel és a bioetanol nem kompatibilisek egymással modern motorokkal.
 fénykép nyílt forrásokból
fénykép nyílt forrásokból
A “motor” megfelelő működéséhez a 5-10% bioüzemanyagok és 90-95% benzin. Láva csapat létrehozta genetikailag módosított E. coli, amely ellentétben a más szintetikus analógok révén bioüzemanyagokat állít elő, amelyek képesek öntsön egy gáztartályba anélkül, hogy bármilyen más üzemanyaggal keveredne. Ennek a megközelítésnek a bioüzemanyagok előállításában előnye az is az üzemanyag-szállítóknak nem kell megváltoztatniuk a meglévőket infrastruktúra (szállítás és forgalmazás). Általában E. coli felszívja a cukrot és zsírokat állít elő sejtképződésre membrán. Egy sajtóközlemény szerint zsírok helyett a mikroorganizmusok szintetikus üzemanyagmolekulákat állítottak elő, tudósok létrehozott egy speciális E. coli törzset. A technológia működésbe lépett szintetikus gyógyászat. Igaz, annak nyilvánvaló ellenére versenyelőny, az új törzs nem lehet nagy sikereket értek el az üzemanyag-pótlók gyártóival. Az új gyártás hatékonysága továbbra is rendkívül alacsony: száz liter a baktériumok és a cukor oldata mindössze egy teáskanálnyi anyagot képes kihozni egy kanál új bioüzemanyag. “Mielőtt továbblépnénk az ipari piacra a termelésnek növelnünk kell a munka hatékonyságát baktériumok. Három-öt év van hátra a teljesítéshez szükséges kísérletek és megértsék, vajon a játék megéri-e a gyertyát, “- A szerelem mondja. Csapata azt is megpróbálja kitalálni, ha Ehelyett a hatékony termelés érdekében az E. coli-t fogyasztják cukor állatok vagy emberi hulladékok. A projekt finanszírozása Shell és a benzines és motorolajok fő gyártója Brit Biológiai és Biotechnológiai Kutatók Tanácsa (BBSRC). Hozzátesszük, hogy a bioüzemanyagokat környezetbarátnak tekintik, mert éppen ilyen mennyiségű szén-dioxidot termel, mely növények képesek feldolgozni. De vannak is alternatív vélemények: Rob Bailey környezetkutató (Rob Bailey) úgy véli, hogy a bioüzemanyagok még a Föld éghajlatát is befolyásolják nagyobb károkat okoznak, mint a fosszilis tüzelőanyagok, beleértve: a gáz szerepel (bővebben ebben a PDF-ben). termelés A bioüzemanyag nem tekinthető a modern orvoslásnak gazdaság, politika és ökológia. Ne feledje, hogy a baktériumok, mint az E. coli, szintén természetes anyag, és ennek megfelelően kevés lehet. Több kutató sok kérdés az üzemanyag előállításával kapcsolatban az E. coliból, mielőtt megvitatnák a gyakorlati tárgyalást a projekt tesztelése és további forgalmazása.
növények






